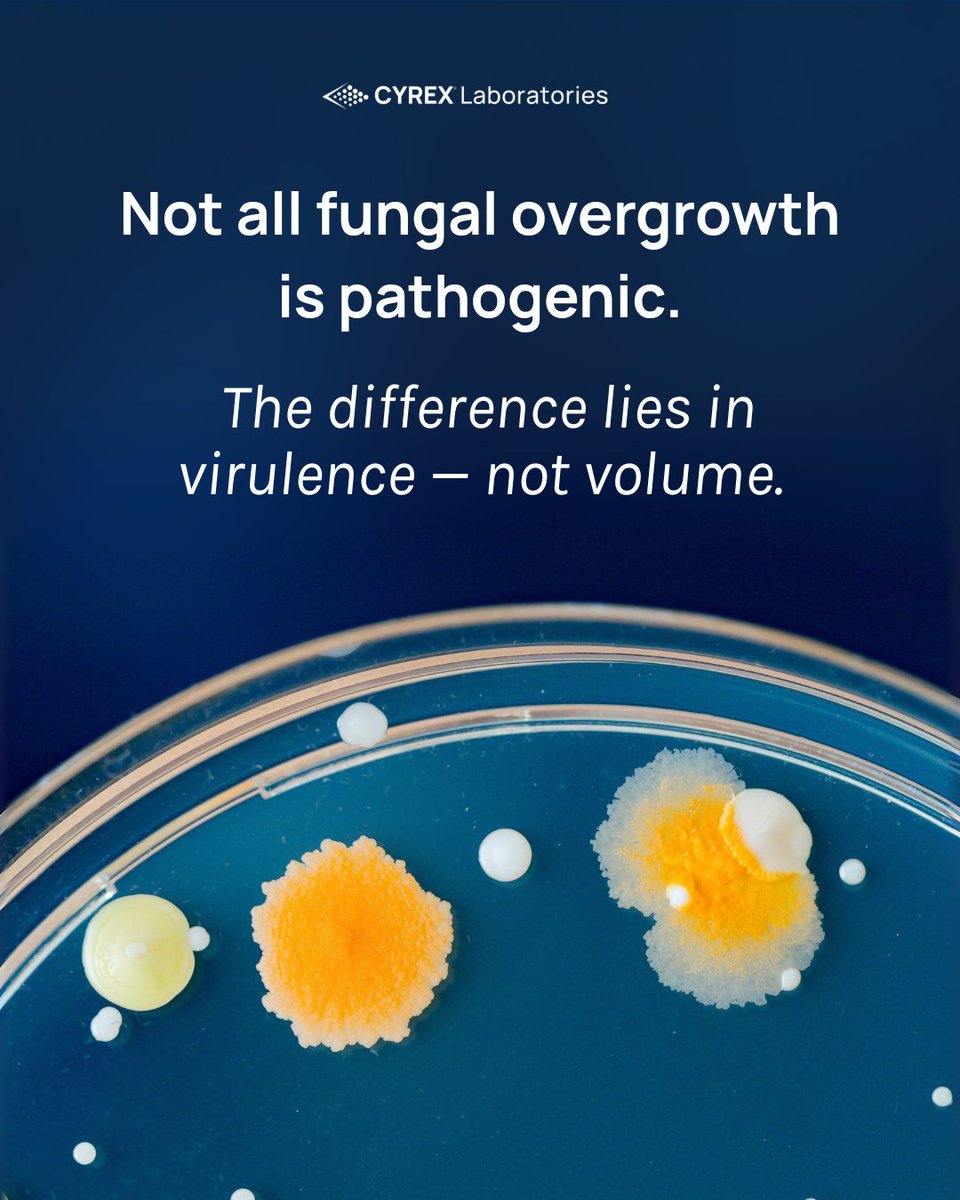
CyrexLabs's tweet image. Most tests tell you if a fungal species is present. But presence alone doesn’t equal pathology. Fungal virulence makes the difference.
BiomeBurden™ Testing Series 
Candida virulence-Multiple fungal species-Mycotoxins 
Available at joincyrex.com

Cyrex Laboratories
@CyrexLabs
True healing starts with the immune system—Cyrex gives you the advanced testing needed to create lasting patient outcomes.
你可能会喜欢
How many women in your practice are still searching for answers? Autoimmunity often begins years before diagnosis. Cyrex panels detect immune reactivity early—before standard labs show damage. joincyrex.com

Dr. Aristo Vojdani shared this insight following the Introducing the BiomeBurden™ Test Series launch—one of many clinical questions sparked by the new panel. 🎥 Want the full breakdown of how BiomeBurden works and when to use it? Watch the replay at joincyrex.com

Most tests tell you if a fungal species is present. But presence alone doesn’t equal pathology. Fungal virulence makes the difference. BiomeBurden™ Testing Series Candida virulence-Multiple fungal species-Mycotoxins Available at joincyrex.com
When standard tests don’t explain the full picture, it’s time to ask: what’s the immune system reacting to? Introducing BiomeBurden™, the first microbiome test series that goes beyond colonization to measure immune reactivity 🔍 Now available at JoinCyrex.com

The immune system speaks long before chronic illness takes hold—you just need the right tools to listen. These four immune markers are part of Cyrex’s immune-first approach to root-cause care. Detect the shift early. Intervene with precision.

At Cyrex, we believe true healing begins when we ask not just what is wrong—but why. Health is shaped by biology, yes—but also by history, hardship, and the world we move through. May our care extend beyond the body, into the systems that shape it.

When the gut barrier breaks, the immune system can lose tolerance—fueling chronic inflammation long before diagnosis. Dr. Andy Barlow’s TED Talk on Syndrome X breaks it down. 🎥 Watch now- youtu.be/ZCtgvk4Tl6I Or visit joincyrex.com to learn more.
We’ve been working on something new—a first-of-its-kind panel that brings the immune system into the gut health conversation. Because symptoms don’t stop at the gut and neither should your testing. Stay tuned...

The future of healthcare is proactive! Focus on wellness through nutrition, exercise, stress management, and regular check-ups to stay ahead of illness. Learn how #TheCyrexSystem can help you take charge of your health: joincyrex.com #ProactiveHealth #PreventionIsPower

The meeting will also be recorded, so you can watch it later on Dr. Weitz's YouTube channel or listen to it as part of his Rational Wellness podcast. For those who don't live in Southern California, below is the link to watch remotely: us02web.zoom.us/j/88452873779p…

Dr. Vojdani will be joining Dr. Ben Weitz & the Functional Medicine Discussion Group to discuss Precision Environmental Health. To attend please RSVP today by sending an email to [email protected] with Vojdani RSVP in the subject line.

How has your diet improved your health? Any symptoms improved so much you no longer need medication? Share your story! #DietAndWellness #FoodIsMedicine #HealthyLiving #BetterHealth #Array10 #HealthJourney

Cyrex Laboratories will be participating in TFIM 2025: Cracking the Code of Chronic Illness in Austin, TX on April 3-6, 2025. Early bird tickets are available through January 31, 2025. To learn more, visit: forumforintegrativemedicine.org

We wish you & your loved ones a joyful holiday season filled with health, happiness & prosperity. May the upcoming year bring even more success and fulfillment. #2025 #HappyNewYear #Healthy2025

This holiday season, give your family the gift of health, with one of our uniquely designed and innovative panels! Why not give something that truly makes a difference? joincyrex.com #HealthyHolidays #CyrexTesting #BetterHealth #Autoimmunity

We want to thank everyone who stopped by our booth this past weekend @A4MEvents 32nd World Congress in Las Vegas, NV. What a great weekend of learning and mingling with fellow functional medicine providers! #A4M #TheCyrexSystem




To ensure the stability of specimen over the holidays, be sure to check out our holiday shipping schedule. #HolidayShipping

United States 趋势
- 1. National Guard 137K posts
- 2. Thanksgiving 442K posts
- 3. Arsenal 320K posts
- 4. Neuer 15.6K posts
- 5. Frank Ragnow 5,858 posts
- 6. #InfoSecVPN N/A
- 7. Bayern 175K posts
- 8. Liverpool 87.9K posts
- 9. Martinelli 13.6K posts
- 10. Konate 9,604 posts
- 11. Mbappe 103K posts
- 12. #ARSBAY 6,362 posts
- 13. Patrick Morrisey 3,209 posts
- 14. Slot 76.3K posts
- 15. Olympiacos 23K posts
- 16. Kimmich 6,105 posts
- 17. Denzel 4,602 posts
- 18. Merino 8,522 posts
- 19. Declan Rice 4,260 posts
- 20. Arteta 20.7K posts
你可能会喜欢
-
 Joseph Pizzorno
Joseph Pizzorno
@drpizzorno -
 David Perlmutter, MD
David Perlmutter, MD
@DavidPerlmutter -
 The Institute for Functional Medicine (IFM)
The Institute for Functional Medicine (IFM)
@fxmed -
 CCNM
CCNM
@myccnm -
 Canadian College of Naturopathic Medicine-Boucher
Canadian College of Naturopathic Medicine-Boucher
@myCCNMBoucher -
 Pure Encapsulations
Pure Encapsulations
@PureEncaps -
 PLMInstitute
PLMInstitute
@PLMInstitute -
 CNELM
CNELM
@CNELM1 -
 IHCAN magazine
IHCAN magazine
@IHCANmagazine -
 BANT
BANT
@BANTonline -
 IHCAN Summit
IHCAN Summit
@IHCANSummit -
 ClinicalEducation
ClinicalEducation
@officialclined -
 GreaterBostonUrology
GreaterBostonUrology
@GBUrology
Something went wrong.
Something went wrong.


















































































































